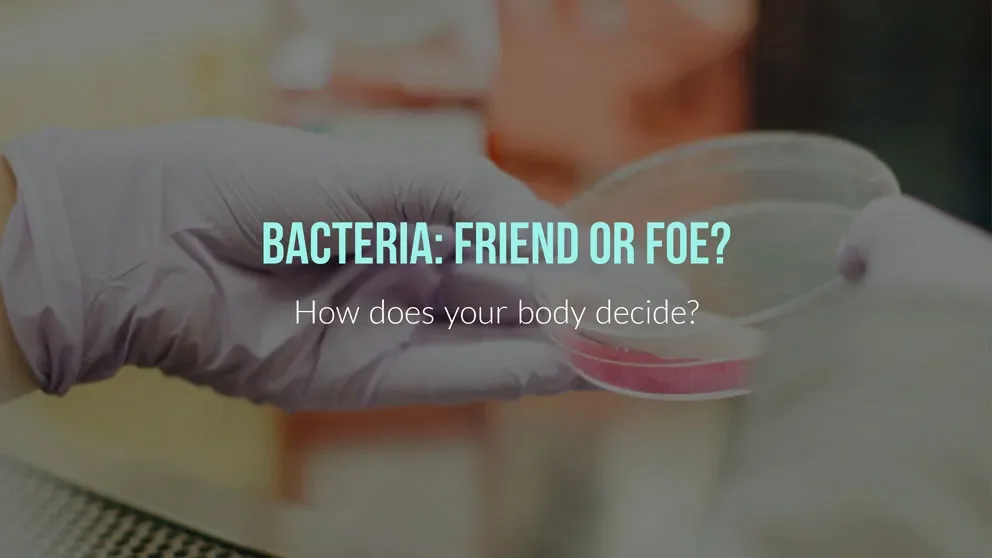
Distinguishing the helpful from the harmful in the human microbiome

Distinguishing the helpful from the harmful in the human microbiome
Research Highlight | September 13, 2018
In school, we learn about the general interaction between microbes such as bacteria and our immune systems in a simple scenario. Upon detection of microbes within or on our body, the immune system activates, attacks the invaders, and ultimately kills them before infection can commence if all goes well. The reality, however, is far more nuanced and complicated.
How, for example, can immune cells distinguish between commensal, or generally helpful, bacterial strains as opposed to potential inflammatory or pathogenic strains? After all, we are awash in bacteria, and the entire collection—our microbiome—contains a huge number of different species. For insight, a team led by JAX Professor Derya Unutmaz and Assistant Professor Julia Oh worked with an immune cell subset, known as mucosal-associated invariant T (MAIT) cells, which express a specific receptor that recognizes a particular bacterial metabolic pathway.
Unutmaz and Oh screened 47 bacterial species from different phyla for their MAIT cell stimulatory capacities. In “Tuning of human MAIT cell activation by commensal bacteria species and MR1-dependent T-cell presentation,” published in Mucosal Immunology, they show that MAIT cells only respond to bacteria that encode the riboflavin biosynthetic pathway, the metabolites of which bind to a molecule known as MR1. But even among riboflavin producing bacterial phyla, the level of stimulation varies depending on the bacteria involved. In general, the high stimulators belonged to theBacteroidetes and Proteobacteria phyla, while Actinobacteria and Firmicutes yielded little or no stimulation. The reasons for the variability between species remains unclear, but differences in the mechanisms underlying the stimulation of and/or synthesis steps in the riboflavin pathways may serve as a regulatory system for bacterial MAIT activation.
Another surprising finding was that MAIT cells can be stimulated, albeit at lower levels, by other T cells. Most T cells have very low MR1 expression compared to the specialized antigen presenting cells (APCs) that typically bind and present the riboflavin metabolites to MAITs. Even in the absence of APCs, however, MAIT stimulation was observed and traced by the team to other T cells. The finding may indicate a way that, in the presence of high levels of riboflavin metabolites, neighboring T cells also activate more MAIT cells, leading to increased inflammation. It is also possible that some T cell subsets, such as regulatory cells, present bacteria metabolites to MAIT cells instead of turning them off to prevent excessive responses. These elaborate interactions may therefore help fine tune the capacity of MAIT cells to discriminate between bacterial species within our microbiota.
The ability of MAIT cells to distinguish bacteria types is likely to be very important, as the normal distribution and proportion of bacterial phyla shift with life history and different disease states within the human microbiome. So how could this play out for our health? For one thing, the ratio ofBacteroidetes to Firmicutes species is much higher in the gut microbiomes of infants than adults. Therefore, more Bacteroidetes may drive MAIT cell expansion early in life, while more Firmicutes mitigates too-strong immune responses within the gut in healthy, steady-state adults. Indeed, Crohn’s disease patients exhibit an increased Bacteroidetes to Firmicutes ratio, in addition to the presence of other pro-MAIT stimulatory species. That skewing of the normal microbiome state may contribute to the chronic inflammation in the gut that’s a hallmark of the disease. These findings may also be relevant to other autoimmune and chronic diseases that the Unutmaz and Oh labs are now investigating, including Myalgic encephalomyelitis/Chronic Fatigue Syndrome. There is also strong evidence of a link between microbiome composition and immune disruptions during aging, another area for further inquiry.
